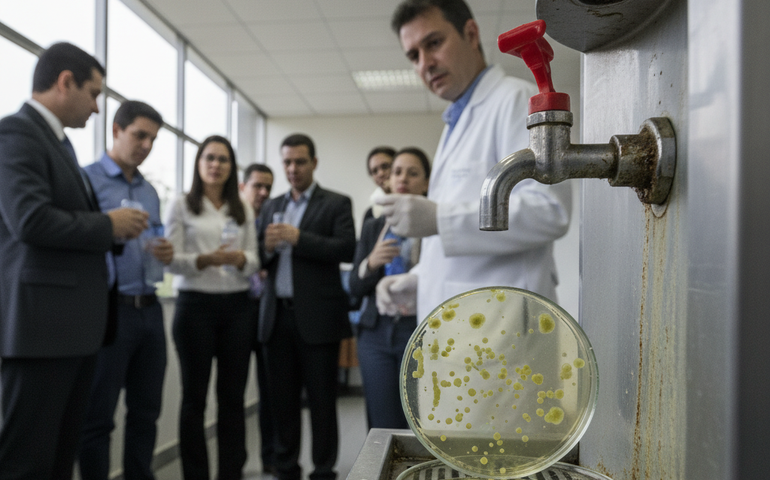
Brasil lidera ranking de contaminação em bebedouros compartilhados, aponta estudo

Vida e Saúde
Brasil lidera ranking de contaminação em bebedouros compartilhados, aponta estudo
Revisão científica revela que mais de 76% dos bebedouros no Brasil apresentam bactérias, superando índices da água da torneira.
Presente em praticamente todos os ambientes de trabalho, o bebedouro — símbolo de pausas rápidas e conversas informais — pode esconder um risco pouco percebido: altos níveis de contaminação bacteriana. Uma revisão abrangente de estudos científicos aponta que, em muitos casos, a água desses equipamentos apresenta mais contaminação do que a própria água da torneira que os abastece.
Estudo internacional revela cenário preocupante
Publicado na revista AIMS Microbiology, o levantamento analisou décadas de pesquisas sobre contaminação em dispensers de água em diversos continentes. Os resultados mostram que, em geral, entre 70% e 80% dos bebedouros avaliados ultrapassaram os limites de segurança bacteriológica em diferentes países e estados dos Estados Unidos.
Brasil lidera estatísticas de contaminação
O dado mais alarmante vem do Brasil. Segundo os estudos reunidos na revisão, mais de 76% dos bebedouros analisados no país apresentaram presença de bactérias, enquanto apenas 36% das amostras de água da torneira mostraram contaminação. A estatística reforça a conclusão de que a água encanada, muitas vezes rejeitada por consumidores, pode ser uma opção mais segura do que a água de bebedouros e máquinas de venda.
Bactérias perigosas e risco à saúde
Entre os microrganismos identificados estão bactérias potencialmente perigosas. A Pseudomonas aeruginosa, por exemplo, representa risco elevado para pessoas imunocomprometidas e pode causar pneumonia, infecções na corrente sanguínea e complicações urinárias. Já as bactérias coliformes — o patógeno mais comum encontrado nas amostras de bebedouros — indicam possível contaminação fecal da água engarrafada.
Bicos dos dispensers concentram mais contaminação
Os bicos dos dispensers aparecem como um dos pontos mais críticos. Diversos estudos apontam que eles podem apresentar até 100 vezes mais contaminação do que outras partes do equipamento, aumentando o risco de transmissão de doenças, já que entram em contato direto com copos e garrafas.
Biofilmes dificultam limpeza eficiente
A principal explicação para o problema está na formação de biofilmes — comunidades de bactérias que se fixam em superfícies internas, como mangueiras, filtros e torneiras, protegidas por uma camada viscosa. Mesmo após limpezas rigorosas, esses biofilmes podem se regenerar em poucos dias. A situação se agrava quando os equipamentos ficam longos períodos sem uso, como à noite ou nos fins de semana, permitindo que a água parada favoreça a multiplicação bacteriana.
Ausência de cloro e materiais inadequados agravam cenário
Outro fator relevante é a ausência de cloro, substância comum nos sistemas municipais de abastecimento e que ajuda a frear o crescimento de microrganismos. Além disso, materiais como mangueiras revestidas de borracha tendem a estimular mais o crescimento bacteriano do que superfícies de vidro ou aço inoxidável.
Falta de regulamentação e necessidade de fiscalização
Apesar de amplamente utilizados, os bebedouros não seguem as mesmas regras rígidas impostas à água municipal pelo Safe Drinking Water Act, nos Estados Unidos, nem por legislações equivalentes em outros países. O estudo reforça a necessidade de manutenção frequente, limpeza adequada e maior fiscalização desses equipamentos — e lança um alerta: no escritório, a água da torneira pode ser menos arriscada do que parece.
Mais lidas
-
1INFRAESTRUTURA
Paulo Dantas anuncia triplicação da rodovia entre Maceió e Barra de São Miguel
-
2DIREITOS TRABALHISTAS
Quando começa a valer a escala 5x2?
-
3JULGAMENTO DO CASO HENRY BOREL
Filha de ex-namorada de Jairinho relata agressões sofridas na infância
-
4EDUCAÇÃO
Vestibular Unicamp 2027: confira os temas mais recorrentes na prova
-
5RESGATE NO LITORAL PAULISTA
Mulher resgatada após mais de 40 horas no mar recebe alta: 'Continuem orando pelo meu colega'


